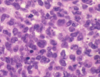

Quiz 2 Flashcards
Dopamine neurons location
Midbrain - Substantia nigra and VTA
Norepinephrine neuron location
Locus ceruleus and medullary reticular formation
Serotonin neuron location
Raphe nuclei in midline of brainstem RF
Acetylcholine neuron location
Basal nucleus
3 divisions of thalamus
Anterior
Medial
Lateral
Anterior nucleus: input and output
Input - Hippocampus –> mammillary body –> AN Output - to Cingulate gyrus (limbic system)
Dorsal medial nucleus
Association nucleus for prefrontal cortex PF–>DMN–>PF
Lateral nucleus divisions
VA
VL
VPL
VPM
Pulvinar
VA/VL nuclei input and output
Input - Motor from cerebellum and basal ganglia
Output - Primary motor, pre motor, supplementary motor
VPL/VPM input and output
Input - STT, Medial lemniscus
Output - To somatosensory cortex
Difference between VPL and VPM
VPM = Smaller, sensory from Trigeminal
VPL = Sensory from rest of body
Auditory thalamus pathway
Auditory nucleus –> Inferior colliculus –> Medial geniculate nucleus –> auditory cortex
Visual thalamus pathway
Optic tract –> Lateral geniculate nucleus –> radiations –> occipital lobe (sup/inf calcarine sulcus)
Pulvinar nucleus pathway
P.O.T –> pulvinar –> P.O.T
Reticular nucleus
Surrounds thalamus
Provides GABAergic inhibitory signals
Provide focus and involved in sleep
Physiological states of thalamocortical neurons
- Tonic mode
- Burst mode
Tonic mode neurons
Regular function, pass along information
Burst mode neurons
Slightly hyperpolarized via RN –> small, slow Ca spike and less iformation transfer
Internal capsule parts
- Anterior limb 2. Genu 3. Posterior limb 4. Sublenticular limb 5. Retrolenticular limb
Anterior limb location
Between caudate lobe and lenticular nucleus
Posterior limb location
Between lenticular nucleus and thalamus
Sublenticular limb location
Below lenticular nucleus
Retrolenticular limb location
Behind lenticular basal ganglia
Contents of anterior limb of internal capsule
Anterior thalamic nuclei fibers Dorsomedial nucleus fibers (PF association)